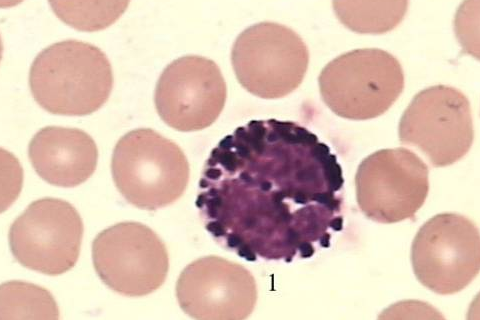
嗜酸性粒细胞偏高是什么原因造成的？
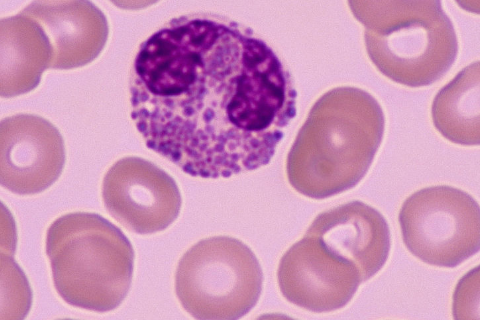
嗜酸性粒细胞偏高是什么原因造成的？

1、寄生虫感染:如线虫病、吸虫病和绦虫病等;
2、变态反应性疾病:如支气管哮喘、过敏性鼻炎、荨麻疹、湿疹和药物过敏反应等;
3、感染性疾病:某些细菌、病毒、真菌和原虫感染可引起嗜酸粒细胞增高;

4、某些恶性血液病和肿瘤:如淋巴瘤、骨髓增殖性肿瘤、胃癌、肺癌和结肠癌等;
5、药物:如青霉素、链霉素、头孢菌素、对氨水杨酸、磺胺、苯妥英钠和氯丙嗪等;
6、免疫性疾病如结节性动脉周围炎、溃疡性结肠炎等等,嗜酸性粒细胞增多还可见于风湿性疾病、内分泌疾病以及一些免疫缺陷病等。
病例分析
嗜酸性粒细胞是白细胞中的一种,通常数量较小,正常参考范围为(0.05-0.5)×109/L,嗜酸细胞增多是指外周血中嗜酸性粒细胞绝对值大于0.5×109/L。
嗜酸性粒细胞增多可由多种原因和多种疾病引起,统称为嗜酸粒细胞增多综合征,其中以寄生虫感染和变态反应性疾病最为常见,随病因不同临床表现可以多种多样。
嗜酸细胞增多极有可能与输入头孢药物有关,药物因素也是导致嗜酸性粒细胞增高的最常见原因,头孢药物可以减少对嗜酸性粒细胞的清除并促进骨髓对嗜酸性粒细胞的释放。
参考资料来源:百度百科-嗜酸性粒细胞
